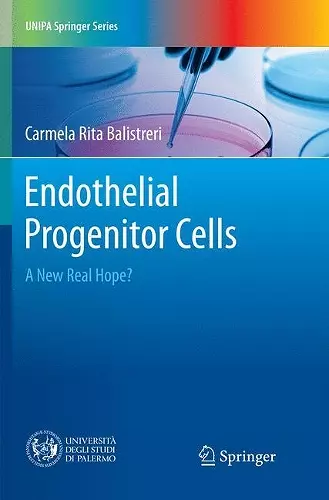
Endothelial Progenitor Cells cover

Endothelial Progenitor Cells
A New Real Hope?
Carmela Rita Balistreri author
Format:Paperback
Publisher:Springer International Publishing AG
Published:2nd Aug '18
Should be back in stock very soon
This book explores the role of endothelial progenitor cells (EPCs) in the context of regenerative medicine (RegMed). In particular, it reveals the value of RegMed as a new TM branch intended to improve the health and quality of life, by restoring, maintaining or enhancing tissue and functions of organs.
The book is divided into three chapters, the first of which describes the relevance of translational medicine (TM) as a new research approach to counteract the imposing challengeof age-related diseases. Of the diverse RegMed approaches, particular attention is paid to stem/progenitor cell-based therapies, their benefits and shortcomings, as well as to the description of types of stem and progenitor cells considered for regenerative cell therapies, such as EPCs as emerging candidates for RegMed applications.
In turn, the second chapter outlines the clinical relevance of EPCs as both potential predictors, diagnostic and prognostic biomarkers of age-related diseases and therapeutic agents,discussing their advantages, disadvantages, and conflicting data.
Chapter three proposes a potential roadmap for revising the findings and creating a clearer picture of valid data, which can provide support for various important aspects, i.e.isolating and characterizing EPCs by establishing standardized criteria for EPC research, identifying appropriate sub-populations for cell therapy, timing, dosing, priming of cells,and defining delivery modes for different applications.
The book concludes with an overview of innovative strategies that could improve the efficacy of cell therapy at all levels, including cell priming, bio-nanotechnology, and tissue engineering.ISBN: 9783319855691
Dimensions: unknown
Weight: unknown
80 pages
Softcover Reprint of the Original 1st 2017 ed.